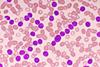
ibrutinib plus venetoclax

All Amanda Cunnington articles
-
 News
NewsNICE recommends first licenced treatment for AL amyloidosis
Having been available in Scotland and Northern Ireland since 2022, NICE’s positive opinion of the combination treatment means it is now accessible on the NHS.
-
News
NewsNICE recommends therapy duo for advanced leukaemia
Janssen states Imbruvica® plus venetoclax will provide "a much-needed new treatment option" for chronic lymphocytic leukaemia.



